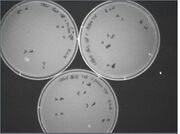

Uploads by Zsun
From OpenWetWare
Jump to navigationJump to search
This special page shows all uploaded files.
| Date | Name | Thumbnail | Size | Description |
|---|---|---|---|---|
| 15:17, 13 August 2012 | TXTL v2 3.xlsx (file) | 15 KB | ||
| 08:26, 17 July 2012 | Plasmid deGFP-070812.xls (file) | 1.13 MB | ||
| 22:09, 26 February 2007 | Apoe ZS.fasta (file) | 4 KB | ||
| 04:57, 3 February 2007 | Code fortranslating.txt (file) | 2 KB | ||
| 22:09, 2 February 2007 | Code1 forT.txt (file) | 1 KB | ||
| 22:05, 2 February 2007 | 2607 kaiC 1.txt (file) | 1 KB | ||
| 21:15, 22 December 2006 | Interaction 2int rotatedcorrect.jpg (file) |  |
9 KB | |
| 21:14, 22 December 2006 | Interaction 2int rotatedcorrect.tif (file) | Error creating thumbnail: convert: Incorrect count for "SampleFormat". `TIFFReadDirectory' @ error/tiff.c/TIFFErrors/542.
convert: no images defined `/home/wiki/public_html/tmp/transform_9558754c6ffa.png' @ error/convert.c/ConvertImageCommand/3234.
Error code: 1 |
154 KB | |
| 21:13, 22 December 2006 | Introtcorr1.tif (file) | Error creating thumbnail: convert: Incorrect count for "SampleFormat". `TIFFReadDirectory' @ error/tiff.c/TIFFErrors/542.
convert: no images defined `/home/wiki/public_html/tmp/transform_edc60c4a955e.png' @ error/convert.c/ConvertImageCommand/3234.
Error code: 1 |
154 KB | |
| 21:12, 22 December 2006 | Botgrap.jpg (file) |  |
16 KB | |
| 21:03, 22 December 2006 | Interaction rotcorr1.tif (file) | Error creating thumbnail: convert: Incorrect count for "SampleFormat". `TIFFReadDirectory' @ error/tiff.c/TIFFErrors/542.
convert: no images defined `/home/wiki/public_html/tmp/transform_545529045713.png' @ error/convert.c/ConvertImageCommand/3234.
Error code: 1 |
121 KB | |
| 21:02, 22 December 2006 | Interaction rotcorr.tif (file) | Error creating thumbnail: convert: Incorrect count for "SampleFormat". `TIFFReadDirectory' @ error/tiff.c/TIFFErrors/542.
convert: no images defined `/home/wiki/public_html/tmp/transform_de86caf58052.png' @ error/convert.c/ConvertImageCommand/3234.
Error code: 1 |
121 KB | |
| 21:01, 22 December 2006 | Oscillation rotcorr.tif (file) |  |
315 KB | |
| 20:58, 22 December 2006 | Interaction rotcorr int2.jpg (file) | Error creating thumbnail: convert: Incorrect count for "SampleFormat". `TIFFReadDirectory' @ error/tiff.c/TIFFErrors/542.
convert: no images defined `/home/wiki/public_html/tmp/transform_c5de113f2f62.png' @ error/convert.c/ConvertImageCommand/3234.
Error code: 1 |
154 KB | |
| 19:35, 19 December 2006 | Cyano notebook.xls (file) | 26 KB | ||
| 02:27, 16 December 2006 | Results1215.jpg (file) |  |
22 KB | |
| 01:19, 15 December 2006 | 1214gel.jpg (file) |  |
17 KB | |
| 22:53, 5 December 2006 | 832xp.jpg (file) |  |
16 KB | |
| 22:52, 5 December 2006 | 335sp.jpg (file) |  |
15 KB | |
| 20:23, 27 October 2006 | Gel resolution zs.jpg (file) |  |
4.59 MB | |
| 20:09, 27 October 2006 | 102706 cyanoresult.jpg (file) |  |
14 KB | |
| 20:04, 27 October 2006 | 102706 cyanoresult.psd (file) | 545 KB | ||
| 20:56, 24 October 2006 | Lig 1024.jpg (file) |  |
10 KB | |
| 21:02, 23 October 2006 | 102306 zspostcut.jpg (file) |  |
18 KB | |
| 21:02, 23 October 2006 | 102306 zsprecut.jpg (file) |  |
13 KB | |
| 05:27, 23 October 2006 | Zs102206.jpg (file) |  |
19 KB | |
| 03:32, 23 October 2006 | ZS102106.jpg (file) |  |
14 KB | |
| 02:25, 19 October 2006 | Colpcr 2 101807.jpg (file) |  |
14 KB | |
| 02:25, 19 October 2006 | Colpcr 1 101806.jpg (file) |  |
16 KB | |
| 23:05, 16 October 2006 | Egel Zs101606.jpg (file) |  |
16 KB | |
| 22:41, 16 October 2006 | 11 ZS101606.jpg (file) |  |
18 KB | |
| 22:41, 16 October 2006 | 10 ZS101606.jpg (file) |  |
15 KB | |
| 01:54, 15 October 2006 | 36010 zs 101406.jpg (file) |  |
16 KB | |
| 21:46, 14 October 2006 | Firstgel 101406.jpg (file) |  |
24 KB | |
| 01:09, 10 October 2006 | ZSHH 100906.jpg (file) |  |
16 KB | |
| 09:47, 30 August 2006 | Dixie.mid (file) | 6 KB | ||
| 09:44, 30 August 2006 | Molar2 830.jpg (file) |  |
15 KB | |
| 09:44, 30 August 2006 | Molar19 830.jpg (file) |  |
15 KB | |
| 09:43, 30 August 2006 | Volume2 830.jpg (file) |  |
16 KB | |
| 09:43, 30 August 2006 | Volume19 830.jpg (file) |  |
15 KB | |
| 06:42, 29 August 2006 | J04500 nanodrop 829.jpg (file) |  |
69 KB | |
| 06:42, 29 August 2006 | Kaic nanodrop 829.jpg (file) |  |
68 KB | |
| 18:37, 28 August 2006 | 2006-8-22digest.jpg (file) |  |
16 KB | |
| 07:34, 28 August 2006 | Final presentation draft2.ppt (file) | 1.71 MB | ||
| 23:47, 21 August 2006 | Digest 821 zs.jpg (file) |  |
16 KB | |
| 05:52, 21 August 2006 | Cyanobacteria presentation Week 10.ppt (file) | 972 KB | ||
| 03:44, 17 August 2006 | Plates 81606.jpg (file) | |
20 KB | |
| 03:43, 17 August 2006 | 12-21 81606.jpg (file) |  |
18 KB | |
| 03:43, 17 August 2006 | 1-11 81606.jpg (file) |  |
18 KB | |
| 14:05, 14 August 2006 | 2006 08 14 egel2.jpg (file) |  |
16 KB |